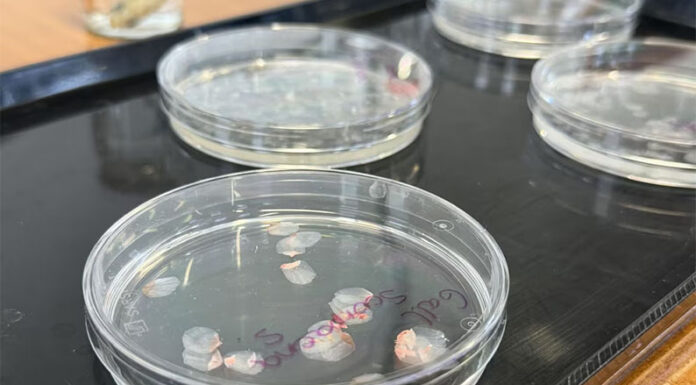
Córneas artificiales hechas de escamas de pescado: cómo este desarrollo podría transformar los trasplantes oculares

Inicio 2026
Archivos anuales: 2026
Locales
Desde Zárate la UCE avanza en su integración al sistema de emergencias en la Región Norte de Bomberos
Redactor EL DEBATE - 0
Representantes de la Unidad Civil de Emergencias participaron de una reunión de jefaturas de la Región Norte Norte de los cuerpos de bomberos de...
Nacionales
Vinos: en medio de una caída histórica del consumo, el enoturismo sale al rescate de la industria vitivinícola global
Redactor EL DEBATE - 0
Experiencias gastronómicas, recorridos por viñedos, hotelería y eventos culturales, convierten a las bodegas en destinos turísticos capaces de compensar la caída de ventas en...
Salud
Por primera vez un estudio hecho en Argentina reveló que el cannabis farmacéutico logró reducir el dolor neuropático central en pacientes con esclerosis múltiple
Redactor EL DEBATE - 0
Es un síntoma debilitante que afecta la calidad de vida de los pacientes y suele ser resistente a los tratamientos tradicionales. Una nueva investigación,...
Provinciales
San Nicolás: Expoagro marcó récords de visitantes, remates y solicitudes de créditos
Redactor EL DEBATE - 0
En su edición número 20, Expoagro confirmó por qué es la mayor muestra agroindustrial del país, un orgullo de San Nicolás y toda la...
Tecnología
Córneas artificiales hechas de escamas de pescado: cómo este desarrollo podría transformar los trasplantes oculares
Redactor EL DEBATE - 0
El avance científico logrado en laboratorios españoles abre nuevas posibilidades para pacientes con enfermedades visuales graves y plantea un futuro donde la escasez de...
Economía
Luis Caputo sobre la inflación: “En septiembre o en octubre” podría ser del 1%
Redactor EL DEBATE - 0
El ministro de Economía analizó por qué la inflación en febrero fue del 2,9%, igual que en enero, y no bajó. Perspectiva para los...
Provinciales
Las boletas de agua llegarán con un plus retroactivo en abril y mayo: los detalles de la suba
Redactor EL DEBATE - 0
En el caso de las personas usuarias residenciales, se suman los montos retroactivos que no pudieron incorporarse en las facturas de febrero y marzo....
Locales
En Zárate, el Colegio de Abogados adquirió su inmueble propio y consolida su crecimiento institucional
Redactor EL DEBATE - 0
El Colegio de Abogados del Departamento Judicial Zárate Campana concretó la compra de su inmueble en la ciudad de Zárate, un paso considerado histórico...
... ANTE EL DOMINIO DE UN MATERIALISMO ASFIXIANTE - “Desvividos por vivir en mística alianza, participaremos de un espíritu cooperante y colaborador, ganaremos en...
Nacionales
Ranking de inflación: en qué posición quedó Argentina en América Latina tras el dato de febrero
Redactor EL DEBATE - 0
Mientras la mayoría de las economías de la región reportaron variaciones inferiores al 1% e incluso deflación, el IPC local consolidó la tendencia alcista...